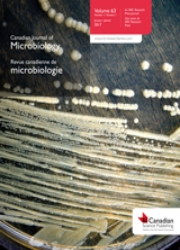

- 充值
- 会员
- 职称材料
搜期刊
刊名
文献信息
- 任意字段
- 主题词
- 篇关摘
- 篇名
- 关键词
- 摘要
- 作者
- 第一作者
- 作者单位
- 刊名
- 中图分类号
- 学科分类号
- DOI
- 基金
首字母查找:
0-9
A
B
C
D
E
F
G
H
I
J
K
L
M
N
O
P
Q
R
S
T
U
V
W
X
Y
Z
共有 86 个结果,以下是21 - 40条
2 / 5
相关度
发文量
影响因子
发文量
7,216
\
被引量
452,285
\
影响因子(2025版)
3.893
发文量
16,913
\
被引量
349,091
\
影响因子(2025版)
3.556
发文量
6,164
\
被引量
340,496
\
影响因子(2025版)
2.871
发文量
5,895
\
被引量
335,676
\
影响因子(2025版)
8.228
发文量
11,867
\
被引量
290,193
\
影响因子(2025版)
1.567
发文量
3,482
\
被引量
249,774
\
影响因子(2025版)
7.064

荷兰
主办单位:SPRINGER
出版周期: 连续出版
别名: WORLD J MICROB BIOT;World J. Microbiol. Biotechnol.;World Journal of Microbiology & Biotechnology;世界微生物学与生物技术杂志;WORLD JOURNAL OF MICROBIOLOGY & BIOTECHNOLOGY;World journal of microbiology & biotechnology
•
曾用名:MIRCEN Journal of Applied Microbiology and Biotechnology
ISSN 0959-3993 / EISSN 1573-0972
发文量
10,066
\
被引量
229,196
\
影响因子(2025版)
4.292
发文量
525
\
被引量
217,936
发文量
10,698
\
被引量
203,136
\
影响因子(2025版)
2.647
发文量
3,954
\
被引量
149,358
\
影响因子(2025版)
2.073
发文量
5,949
\
被引量
148,195
\
影响因子(2025版)
3.023
发文量
3,850
\
被引量
127,123
\
影响因子(2025版)
2.171
发文量
848
\
被引量
104,519
发文量
6,008
\
被引量
97,355
\
影响因子(2025版)
1.943
发文量
6,077
\
被引量
79,943
\
影响因子(2025版)
2.516
发文量
14,202
\
被引量
78,097
\
影响因子(2025版)
0.532
发文量
2,855
\
被引量
72,924
\
影响因子(2025版)
4.343
发文量
1,554
\
被引量
71,132
\
影响因子(2025版)
7.941
发文量
9,718
\
被引量
70,825
\
影响因子(2025版)
2.381
发文量
3,185
\
被引量
70,765
\
影响因子(2025版)
2.451
重庆维普资讯有限公司
渝B2-20050021-1 渝公网备 50019002500403
违法和不良信息举报中心 举报邮箱:jubao@cqvip.com 互联网算法推荐专项举报:sfjubao@cqvip.com
网络暴力专项举报: bljubao@cqvip.com
网络出版:(署)网出证(渝)字第014号
出版物经营许可证:新出发2018批字第006号
关于旧版官网用户迁移的说明